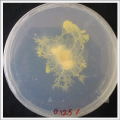

Showing below up to 50 results in range #1 to #50.
- (1).jpg 3,000 × 2,000; 5.77 MB
- (1348) Nunu Bot Special Interactions - YouTube - Google Chrome 19.02.2021 19 11 45.png 1,801 × 1,011; 1.54 MB
- (1367) Viego's Voice Lines Explained - YouTube - Google Chrome 20.02.2021 16 24 39.png 1,920 × 1,080; 3.53 MB
- (R)Evolution ressources.zip ; 16.19 MB
- (mis)placed desires 1.png 1,920 × 1,080; 140 KB
- (mis)placed desires 2.png 1,920 × 1,080; 228 KB
- (mis)placed desires 3.png 1,920 × 1,080; 1.86 MB
- -&-werehere.wiki.jpg 780 × 529; 60 KB
- ....jpg 3,477 × 1,441; 456 KB
- ///C:/Users/User/Desktop/bacterial-cellulose-v5.pdf///C:/Users/User/Desktop/bacterial-cellulose-v5.pdf File missing
- 0% salinity.png 1,164 × 1,162; 2.24 MB
- 0-1.jpg 4,032 × 3,024; 1.89 MB
- 0-2.jpg 4,032 × 3,024; 1.56 MB
- 0-9.JPG 600 × 800; 102 KB
- 0-PhotoCellA0.png 1,212 × 1,002; 183 KB
- 0-atom.png 972 × 449; 164 KB
- 0-kit.jpg 3,264 × 2,448; 2.3 MB
- 0.062% salinity.png 1,164 × 1,162; 1.9 MB
- 0.125% salinity.png 1,164 × 1,162; 2.05 MB
- 0.25% salinity.png 1,164 × 1,162; 1.79 MB
- 0.5% salinity.png 1,164 × 1,162; 2.03 MB
- 0.icon.1.png 466 × 616; 66 KB
- 0.jpg 2,547 × 1,512; 384 KB
- 00-maxsmp.png 3,456 × 2,234; 570 KB
- 00-random-sound.maxpat ; 7 KB
- 00-sequencer.maxpat ; 7 KB
- 00-tutorial-forms.maxpat ; 7 KB
- 00..jpg 1,024 × 768; 714 KB
- 000.jpg 1,000 × 741; 75 KB
- 0000000.jpg 215 × 148; 12 KB
- 0000000000Untitled-1.jpg 2,371 × 629; 937 KB
- 0000000003-0000000004-0000000023.JPG 1,504 × 1,000; 645 KB
- 0000000005-0000000005-0000000023.JPG 1,504 × 1,000; 598 KB
- 0000000005-0000000005-0000000023.thumb.jpg 250 × 166; 58 KB
- 0000000006-0000000006-0000000023.JPG 1,504 × 1,000; 613 KB
- 0000000014-0000000019-0000000005-0000000023.JPG 1,504 × 1,000; 799 KB
- 0000000074-0000000075.JPG 1,504 × 1,000; 206 KB
- 0000000086-0000000026.JPG 1,504 × 1,000; 535 KB
- 00001920.pdf ; 157 KB
- 0001.jpg 800 × 800; 58 KB
- 000 model lumDance copy.jpg 3,076 × 1,893; 1.6 MB
- 001.jpg 1,024 × 768; 227 KB
- 001.png 1,030 × 1,174; 680 KB
- 0018.JPG 3,648 × 3,648; 2.38 MB
- 001 a.png 1,267 × 1,798; 806 KB
- 002.jpg 1,024 × 768; 333 KB
- 002.png 1,030 × 1,176; 1.05 MB
- 0023.JPG 3,648 × 3,648; 2.53 MB